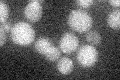
YOR301W
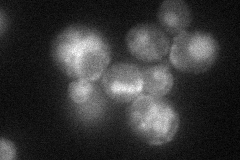
YOR301W
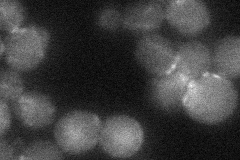
YOR301W
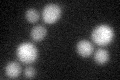
YOR301W

View description
Protein involved in bud site selection during bipolar budding; localization requires Rax2p; has similarity to members of the insulin-related peptide superfamily
Localization:
Intensity:
Fold change:
Significance:
-
C’ GFP library in SD
below threshold15.55 -
N' NOP1pr-GFP in SD
vacuole,bud neck32.3186 -
N' TEF2pr-mCherry in SD

vacuole39.493 -
N' NATIVEpr-GFP in SD
bud neck19.7642 -
N' TEF2pr-VC and Cyto-VN in SD

below threshold23.8221 -
C’ GFP library in SD+DTT
cytosol16.981.09No -
C’ GFP library in SD+H2O2

cytosol16.41.05No -
C’ GFP library in Starvation Media

cytosol17.431.12No -
C’ GFP library on the background of Pup2-DaMP

below threshold -
C’ GFP library on the background of CCT mutant

below threshold16.47171.05859No
